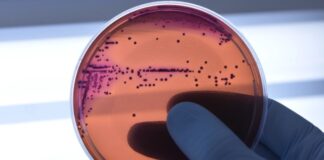
Medicamento promissor pode combater a resistência bacteriana aos antibióticos

Posts Recentes
EduSesc transforma educação e forma jovens líderes no DF
EduSesc forma cidadãos protagonistas e reforça compromisso com a excelência na educação do DF
Em entrevista ao programa Supera Brasília, conduzido pelo jornalista Josiel Ferreira, a professora Riquelle...
Senac-DF abre inscrições para o curso de ajustes e reformas do...
Com início em 24 de novembro, curso oferece formação prática para quem deseja aperfeiçoar técnicas de costura e ampliar oportunidades no mercado da moda.
O...
Daniel Vilela é destaque na Veja como nome forte para 2026
Revista nacional aponta o vice-governador como um dos nomes mais fortes do país para a sucessão em 2026A Revista Veja destacou nesta semana o vice-governador de...
GDF mobiliza esforços no Dia D Contra a Dengue
Ação na UBS 1 da Asa Sul contou com ações educativas, vacinação e soltura de Wolbitos Neste sábado (8) foi realizado o Dia D de Mobilização Nacional Contra...
Força Nacional do SUS atua em Rio Bonito do Iguaçu após...
Ministério da Saúde envia equipe especializada para restaurar serviços de saúde, prestar apoio psicossocial e avaliar riscos sanitários após destruição de 90% da área...